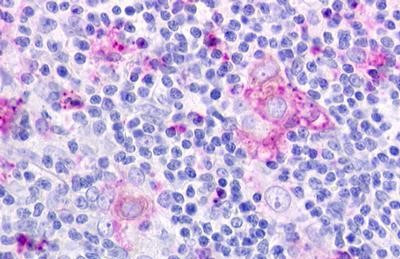
CMKLR1 Antibody in Immunohistochemistry (Paraffin) (IHC (P))

Search
Invitrogen
CMKLR1 Polyclonal Antibody
{{$productOrderCtrl.translations['antibody.pdp.commerceCard.promotion.promotions']}}
{{$productOrderCtrl.translations['antibody.pdp.commerceCard.promotion.viewpromo']}}
{{$productOrderCtrl.translations['antibody.pdp.commerceCard.promotion.promocode']}}: {{promo.promoCode}} {{promo.promoTitle}} {{promo.promoDescription}}. {{$productOrderCtrl.translations['antibody.pdp.commerceCard.promotion.learnmore']}}
产品信息
PA5-33437
种属反应
宿主/亚型
分类
类型
抗原
偶联物
形式
浓度
规格
纯化类型
保存液
内含物
保存条件
运输条件
RRID
靶标信息
Chemokine-like receptor 1 (CMKLR1) is a receptor for the chemoattractant adipokine chemerin/RARRES2 and for the omega-3 fatty acid derived molecule resolvin E1. Interaction with RARRES2 induces activation of intracellular signaling molecules, such as SKY, MAPK1/3 (ERK1/2), MAPK14/P38MAPK and PI3K leading to multifunctional effects, like, reduction of immune responses, enhancing of adipogenesis and angionesis. Resolvin E1 down-regulates cytokine production in macrophages by reducing the activation of MAPK1/3 (ERK1/2) and NF-kappa-B. CMKLR1 positively regulates adipogenesis and adipocyte metabolism and acts as a coreceptor for several SIV strains (SIVMAC316, SIVMAC239, SIVMACL7E-FR and SIVSM62A), as well as a primary HIV-1 strain (92UG024-2).
仅用于科研。不用于诊断过程。未经明确授权不得转售。
篇参考文献 (0)
生物信息学
蛋白别名: chemerin receptor; Chemerin-like receptor 1; chemokine receptor-like 1; Chemokine-like receptor 1; G-protein coupled receptor; G-protein coupled receptor ChemR23; G-protein coupled receptor DEZ; orphan G-protein coupled receptor, Dez; resolvin E1 receptor; unnamed protein product
基因别名: CHEMERINR; CHEMR23; CMKLR1; DEZ; ERV1; RVER1
UniProt ID: (Human) Q99788
Entrez Gene ID: (Rabbit) 100355497, (Dog) 486321, (Human) 1240